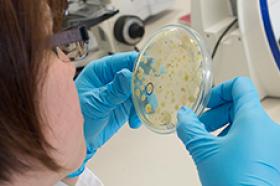

Charla informativa movilidad saliente Facultad Ciencias Sociales
International Students
Estudiantes Internacionales
Charla informativa movilidad saliente Facultad Ciencias Sociales
¿Qué debo Saber?
-
Bienvenidos a la UTadeo, un lugar donde la ciencia y el arte se encuentran, anímate a vivir una experiencia internacional con nosotros ¡Te esperamos!Requisitos Estudiantes Extranjeros:
- Ingresa en el siguiente link y diligencia el formulario de inscripción. Escoge la opción de "Convenios" - https://appsia.utadeo.edu.co/
formularioBasico/inicio.jsp - Necesitas dos fotografías tamaño pasaporte.
- Una fotocopia de la visa que te identifica como estudiante. - https://www.cancilleria.gov.
co/tramites_servicios/visas/ clases - El certificado de notas hasta el último periodo académico cursado con promedio académico, traducido al español.
- Debes tener una autorización por escrito del director de tu programa con las asignaturas que deseas cursar en la Universidad Jorge Tadeo Lozano.
- Requieres un certificado médico.
- Un seguro médico con cobertura internacional.
- En caso de que seas menor de edad en tu país de origen, requieres una carta de tus padres o acudientes autorizando tu participación en el programa de intercambio y garantizando tu compromiso de apoyo económico por el período que vayas a permanecer en Colombia.
- Debes cumplir con el reglamento de estudiantes de la Universidad Jorge Tadeo Lozano. (Ver reglamento).
- Ingresa en el siguiente link y diligencia el formulario de inscripción. Escoge la opción de "Convenios" - https://appsia.utadeo.edu.co/